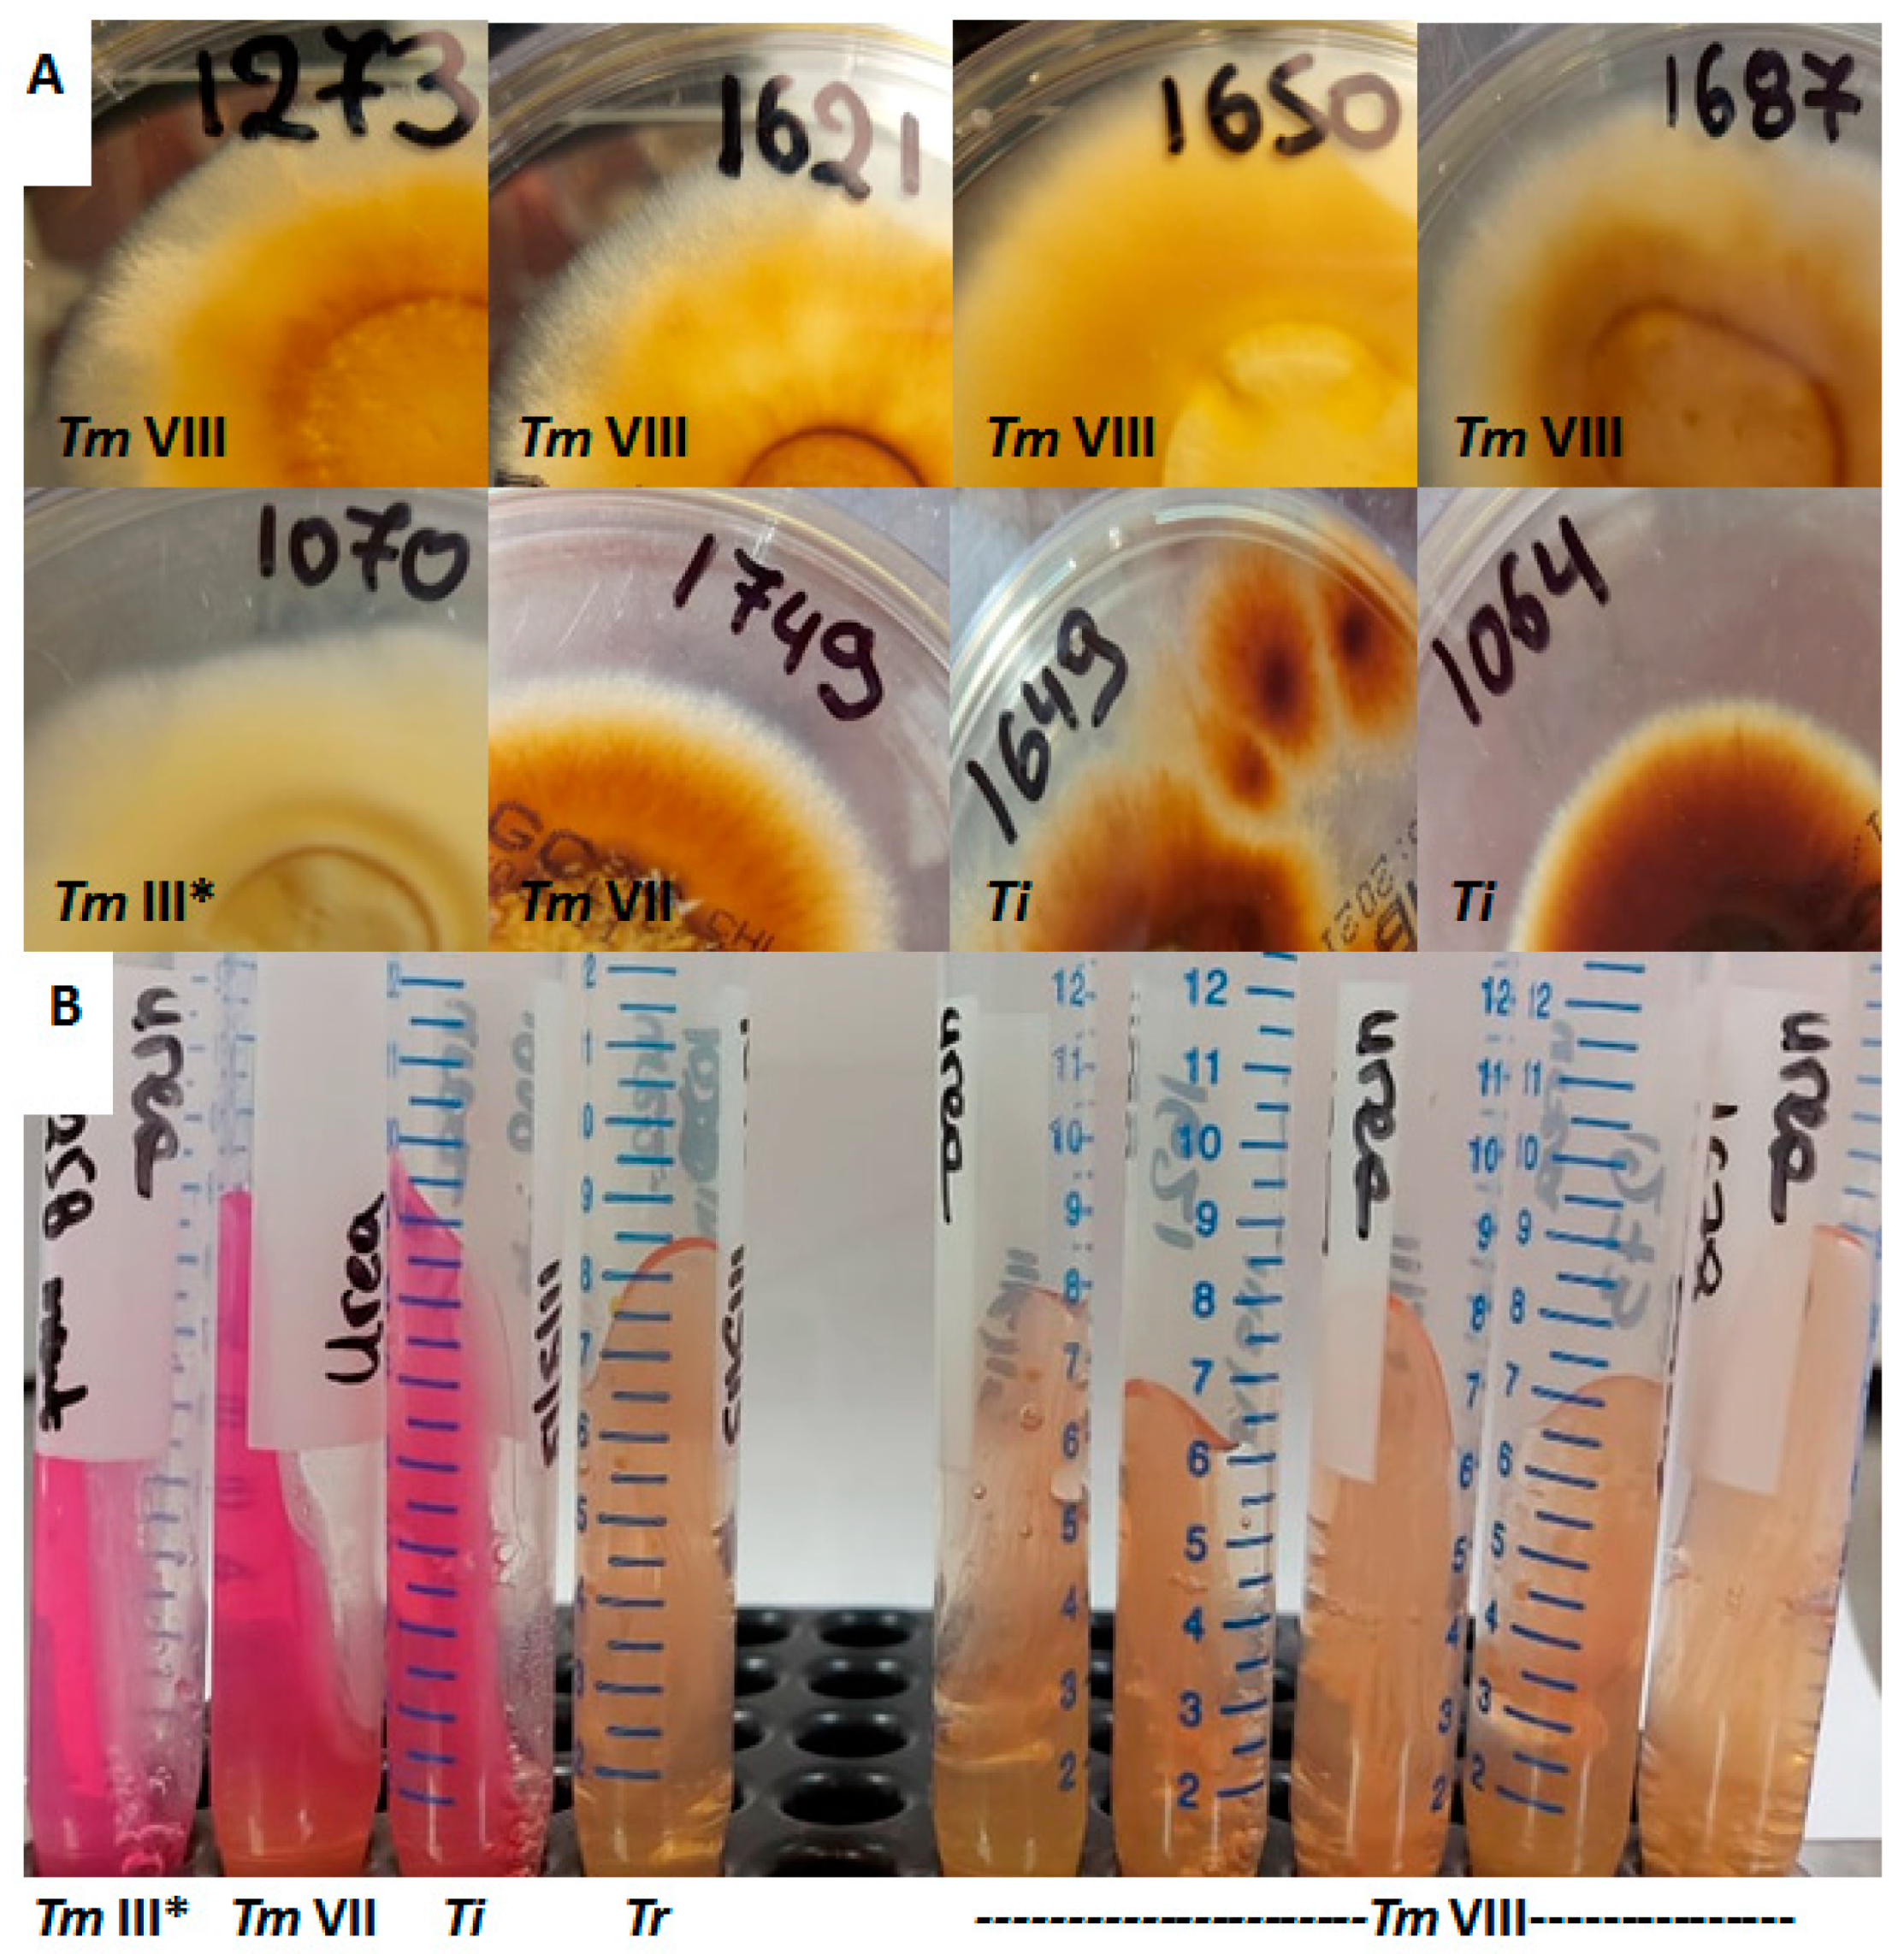
Jof 07 00419 g002 Jof 07 00419 g002

Molecular Epidemiology and Antifungal Susceptibility of Trichophyton Isolates in Greece: Emergence of Terbinafine-Resistant Trichophytonmentagrophytes Type VIII Locally and Globally
Abstract
1. Introduction
2. Materials and Methods
2.1. Fungal Isolates
2.2. Molecular Identification
2.3. Antifungal Susceptibility Testing
2.4. Molecular Analysis of the Gene Encoding SQLE
3. Results
3.1. Identification
3.2. Origin of Isolates
3.3. Antifungal Susceptibility
3.4. Non-WT Phenotypes
4. Discussion
Author Contributions
Funding
Institutional Review Board Statement
Informed Consent Statement
Data Availability Statement
Conflicts of Interest
References
- Havlickova, B.; Czaika, V.A.; Friedrich, M. Epidemiological trends in skin mycoses worldwide. Mycoses 2008, 51, 2–15. [Google Scholar] [CrossRef]
- Benedict, K.; Jackson, B.R.; Chiller, T.; Beer, K.D. Estimation of Direct Healthcare Costs of Fungal Diseases in the United States. Clin. Infect. Dis. 2019, 68, 1791–1797. [Google Scholar] [CrossRef]
- Fiammenghi, E.; Patalano, A.; Conte, V.L.; Calabrò, G. Cost analysis of inappropriate treatments for suspected dermatomycoses. Farmeconomia Health Econ. Ther. Pathw. 2015, 16, 39–44. [Google Scholar] [CrossRef][Green Version]
- Monod, M. Antifungal resistance in dermatophytes: Emerging problem and challenge for the medical community. J. Med. Mycol. 2019, 29, 283–284. [Google Scholar] [CrossRef]
- Hay, R. Therapy of Skin, Hair and Nail Fungal Infections. J. Fungi 2018, 4, 99. [Google Scholar] [CrossRef] [PubMed]
- Ebert, A.; Monod, M.; Salamin, K.; Burmester, A.; Uhrlaß, S.; Wiegand, C.; Hipler, U.; Krüger, C.; Koch, D.; Wittig, F.; et al. Alarming India-wide phenomenon of antifungal resistance in dermatophytes: A multicentre study. Mycoses 2020, 63, 717–728. [Google Scholar] [CrossRef]
- Saunte, D.M.L.; Hare, R.K.; Jørgensen, K.M.; Jørgensen, R.; Deleuran, M.; Zachariae, C.O.; Thomsen, S.F.; Bjørnskov-Halkier, L.; Kofoed, K.; Arendrup, M.C. Emerging Terbinafine Resistance in Trichophyton: Clinical Characteristics, Squalene Epoxidase Gene Mutations, and a Reliable EUCAST Method for Detection. Antimicrob. Agents Chemother. 2019, 63. [Google Scholar] [CrossRef] [PubMed]
- Salehi, Z.; Shams-Ghahfarokhi, M.; Razzaghi-Abyaneh, M. Antifungal drug susceptibility profile of clinically important dermatophytes and determination of point mutations in terbinafine-resistant isolates. Eur. J. Clin. Microbiol. Infect. Dis. 2018, 37, 1841–1846. [Google Scholar] [CrossRef] [PubMed]
- Yamada, T.; Maeda, M.; Alshahni, M.M.; Tanaka, R.; Yaguchi, T.; Bontems, O.; Salamin, K.; Fratti, M.; Monod, M. Terbinafine Resistance of Trichophyton Clinical Isolates Caused by Specific Point Mutations in the Squalene Epoxidase Gene. Antimicrob. Agents Chemother. 2017, 61, e00115-17. [Google Scholar] [CrossRef]
- Singh, A.; Masih, A.; Khurana, A.; Singh, P.K.; Gupta, M.; Hagen, F.; Meis, J.F.; Chowdhary, A. High terbinafine resistance in Trichophyton interdigitale isolates in Delhi, India harbouring mutations in the squalene epoxidase gene. Mycoses 2018, 61, 477–484. [Google Scholar] [CrossRef]
- Fattahi, A.; Shirvani, F.; Ayatollahi, A.; Rezaei-Matehkolaei, A.; Badali, H.; Lotfali, E.; Ghasemi, R.; Pourpak, Z.; Firooz, A. Multi-drug-resistant Trichophyton mentagrophytes genotype VIII in an Iranian family with generalized dermatophytosis: Report of four cases and review of literature. Int. J. Dermatol. 2020. [Google Scholar] [CrossRef]
- Nenoff, P.; Verma, S.B.; Ebert, A.; Süß, A.; Fischer, E.; Auerswald, E.; Dessoi, S.; Hofmann, W.; Schmidt, S.; Neubert, K.; et al. Spread of Terbinafine-Resistant Trichophyton mentagrophytes Type VIII (India) in Germany–“The Tip of the Iceberg?”. J. Fungi 2020, 6, 207. [Google Scholar] [CrossRef] [PubMed]
- Rudramurthy, S.M.; Dogra, S.; Shaw, D. Antifungal drug susceptibility testing of dermatophytes: Laboratory findings to clinical implications. Indian Dermatol. Online J. 2019, 10, 225–233. [Google Scholar] [CrossRef]
- Arendrup, M.C.; Kahlmeter, G.; Guinea, J.; Meletiadis, J.; Arikan-Akdagli, S.; Friberg, N.; Barchiesi, F.; Castanheira, M.; Hamal, P.; Järv, H.; et al. How to: Perform antifungal susceptibility testing of microconidia-forming dermatophytes following the new reference EUCAST method E.Def 11.0, exemplified by Trichophyton. Clin. Microbiol. Infect. 2021, 27, 55–60. [Google Scholar] [CrossRef] [PubMed]
- De Hoog, G.S.; Gene, J.; Ahmed, S.; Al-Hatmi, A.M.S.; Figueras, M.J.; Vitale, R.G. Atlas of Clinical Fungi; Amer Society for Microbiology: Washington, DC, USA, 2001; ISBN 9789070351434. [Google Scholar]
- Alastruey-Izquierdo, A.; Mellado, E.; Peláez, T.; Pemán, J.; Zapico, S.; Alvarez, M.; Rodríguez-Tudela, J.L.; Cuenca-Estrella, M. FILPOP Study Group Population-Based Survey of Filamentous Fungi and Antifungal Resistance in Spain (FILPOP Study). Antimicrob. Agents Chemother. 2013, 57, 3380–3387. [Google Scholar] [CrossRef]
- Habeb, K.A.; Maikhan, H.K.; Rachid, S.K. Molecular Identification of Dermatophytes among Clinical Isolates. Asian J. Nat. Appl. Sci. 2016, 5, 108–118. [Google Scholar]
- Nenoff, P.; Verma, S.B.; Uhrlaß, S.; Burmester, A.; Gräser, Y. A clarion call for preventing taxonomical errors of dermatophytes using the example of the novel Trichophyton mentagrophytes genotype VIII uniformly isolated in the Indian epidemic of superficial dermatophytosis. Mycoses 2018, 62, 6–10. [Google Scholar] [CrossRef]
- Lipner, S.R.; Scher, R.K. Onychomycosis: Treatment and prevention of recurrence. J. Am. Acad. Dermatol. 2019, 80, 853–867. [Google Scholar] [CrossRef]
- Kumar, S.; Stecher, G.; Li, M.; Knyaz, C.; Tamura, K. MEGA X: Molecular evolutionary genetics analysis across computing platforms. Mol. Biol. Evol. 2018, 35, 1547–1549. [Google Scholar] [CrossRef]
- Taghipour, S.; Pchelin, I.M.; Mahmoudabadi, A.Z.; Ansari, S.; Katiraee, F.; Rafiei, A.; Shokohi, T.; Abastabar, M.; Taraskina, A.E.; Kermani, F.; et al. Trichophyton mentagrophytes and T. interdigitale genotypes are associated with particular geographic areas and clinical manifestations. Mycoses 2019, 62, 1084–1091. [Google Scholar] [CrossRef]
- Nenoff, P.; Verma, S.B.; Vasani, R.; Burmester, A.; Hipler, U.; Wittig, F.; Krüger, C.; Nenoff, K.; Wiegand, C.; Saraswat, A.; et al. The current Indian epidemic of superficial dermatophytosis due to Trichophyton mentagrophytes—A molecular study. Mycoses 2018, 62, 336–356. [Google Scholar] [CrossRef]
- Heidemann, S.; Monod, M.; Gräser, Y. Signature polymorphisms in the internal transcribed spacer region relevant for the differentiation of zoophilic and anthropophilic strains of Trichophyton interdigitale and other species of T. mentagrophytes sensu lato. Br. J. Dermatol. 2009, 162, 282–295. [Google Scholar] [CrossRef]
- Klinger, M.; Theiler, M.; Bosshard, P. Epidemiological and clinical aspects of Trichophyton mentagrophytes/Trichophyton interdigitale infections in the Zurich area: A retrospective study using genotyping. J. Eur. Acad. Dermatol. Venereol. 2021, 35, 1017–1025. [Google Scholar] [CrossRef] [PubMed]
- Kupsch, C.; Czaika, V.; Deutsch, C.; Gräser, Y. Trichophyton mentagrophytes—a new genotype of zoophilic dermatophyte causes sexually transmitted infections. J. Dtsch. Dermatol. Ges. 2019, 17, 493–501. [Google Scholar] [CrossRef] [PubMed]
- Süß, A.; Uhrlaß, S.; Ludes, A.; Verma, S.B.; Monod, M.; Krüger, C.; Nenoff, P. Ausgeprägte Tinea corporis durch ein Terbinafin-resistentes Trichophyton-mentagrophytes-Isolat vom indischen Genotyp bei einem Säugling aus Bahrain in Deutschland. Der Hautarzt 2019, 70, 888–896. [Google Scholar] [CrossRef]
- Amnesty International, Trapped in Greece: An Avoidable Refugee Crisis. Available online: https://www.refworld.org/docid/571db6df4.html (accessed on 13 March 2021).
- Dogra, S.; Kaul, S.; Yadav, S. Treatment of dermatophytosis in elderly, children, and pregnant women. Indian Dermatol. Online J. 2017, 8, 310–318. [Google Scholar] [CrossRef] [PubMed]
- Rouzaud, C.; Chosidow, O.; Brocard, A.; Fraitag, S.; Scemla, A.; Anglicheau, D.; Bouaziz, J.-D.; Dupin, N.; Bougnoux, M.-E.; Hay, R.; et al. Severe dermatophytosis in solid organ transplant recipients: A French retrospective series and literature review. Transpl. Infect. Dis. 2018, 20, e12799. [Google Scholar] [CrossRef]
- Liu, H.B.; Liu, F.; Kong, Q.T.; Shen, Y.N.; Lv, G.X.; Liu, W.D.; Sang, H. Successful Treatment of Refractory Majocchi’s Granuloma with Voriconazole and Review of Published Literature. Mycopathologia 2015, 180, 237–243. [Google Scholar] [CrossRef]
- Bhatia, V.; Sharma, P. Determination of minimum inhibitory concentrations of itraconazole, terbinafine and ketoconazole against dermatophyte species by broth microdilution method. Indian J. Med Microbiol. 2015, 33, 533–537. [Google Scholar] [CrossRef]
- Hiruma, J.; Noguchi, H.; Hase, M.; Tokuhisa, Y.; Shimizu, T.; Ogawa, T.; Hiruma, M.; Harada, K.; Kano, R. Epidemiological study of terbinafine-resistant dermatophytes isolated from Japanese patients. J. Dermatol. 2021, 48, 564–567. [Google Scholar] [CrossRef]
- Shankarnarayan, S.A.; Shaw, D.; Sharma, A.; Chakrabarti, A.; Dogra, S.; Kumaran, M.S.; Kaur, H.; Ghosh, A.; Rudramurthy, S.M. Rapid detection of terbinafine resistance in Trichophyton species by Amplified refractory mutation system-polymerase chain reaction. Sci. Rep. 2020, 10, 1297. [Google Scholar] [CrossRef] [PubMed]
- Rezaei-Matehkolaei, A.; Khodavaisy, S.; Alshahni, M.M.; Tamura, T.; Satoh, K.; Abastabar, M.; Shokoohi, G.R.; Ahmadi, B.; Kord, M.; Taghipour, S.; et al. In Vitro Antifungal Activity of Novel Triazole Efinaconazole and Five Comparators against Dermatophyte Isolates. Antimicrob. Agents Chemother. 2018, 62, e02423-17. [Google Scholar] [CrossRef]
- Ansari, S.; Hedayati, M.T.; Zomorodian, K.; Pakshir, K.; Badali, H.; Rafiei, A.; Ravandeh, M.; Seyedmousavi, S. Molecular Characterization and In Vitro Antifungal Susceptibility of 316 Clinical Isolates of Dermatophytes in Iran. Mycopathologia 2016, 181, 89–95. [Google Scholar] [CrossRef]
- Gu, D.; Hatch, M.; Ghannoum, M.; Elewski, B.E. Treatment-resistant dermatophytosis: A representative case highlighting an emerging public health threat. JAAD Case Rep. 2020, 6, 1153–1155. [Google Scholar] [CrossRef] [PubMed]
- Noguchi, H.; Matsumoto, T.; Hiruma, M.; Kimura, U.; Kano, R.; Yaguchi, T.; Fukushima, S.; Ihn, H. Tinea unguium caused by terbinafine-resistant Trichophyton rubrum successfully treated with fosravuconazole. J. Dermatol. 2019, 46, e446–e447. [Google Scholar] [CrossRef] [PubMed]
- Schøsler, L.; Andersen, L.K.; Arendrup, M.C.; Sommerlund, M. Recurrent terbinafine resistant Trichophyton rubrum infection in a child with congenital ichthyosis. Pediatr. Dermatol. 2018, 35, 259–260. [Google Scholar] [CrossRef]
- Wingfield Digby, S.S.; Hald, M.; Arendrup, M.C.; Hjorth, S.V.; Kofoed, K. Darier disease complicated by terbinafine-resistant Trichophyton rubrum: A case report. Acta Derm. Venereol. 2017, 97, 139–140. [Google Scholar] [CrossRef]
- Suzuki, S.; Mano, Y.; Furuya, N.; Fujitani, K. Discovery of Terbinafine Low Susceptibility Trichophyton rubrum strain in Japan. Biocontrol Sci. 2018, 23, 151–154. [Google Scholar] [CrossRef]
- Nizam, T.M.; Binting, R.A.A.; Saari, S.M.; Kumar, T.V.; Muhammad, M.; Satim, H.; Yusoff, H.; Santhanam, J. In Vitro Antifungal Activities against Moulds Isolated from Dermatological Specimens. Malays. J. Med. Sci. 2016, 23, 32–39. [Google Scholar]
- Osborne, C.S.; Leitner, I.; Hofbauer, B.; Fielding, C.A.; Favre, B.; Ryder, N.S. Biological, Biochemical, and Molecular Characterization of a New Clinical Trichophyton rubrum Isolate Resistant to Terbinafine. Antimicrob. Agents Chemother. 2006, 50, 2234–2236. [Google Scholar] [CrossRef]
- Mukherjee, P.K.; Leidich, S.D.; Isham, N.; Leitner, I.; Ryder, N.S.; Ghannoum, M.A. Clinical Trichophyton rubrum Strain Exhibiting Primary Resistance to Terbinafine. Antimicrob. Agents Chemother. 2003, 47, 82–86. [Google Scholar] [CrossRef] [PubMed]
- Maurya, V.K.; Kachhwaha, D.; Bora, A.; Khatri, P.K.; Rathore, L. Determination of antifungal minimum inhibitory concentration and its clinical correlation among treatment failure cases of dermatophytosis. J. Fam. Med. Prim. Care 2019, 8, 2577–2581. [Google Scholar] [CrossRef]
- Dogra, S.; Pathania, S.; Rudramurthy, S.; Narang, T.; Saikia, U. A prospective study of the epidemiological and clinical patterns of recurrent dermatophytosis at a tertiary care hospital in India. Indian J. Dermatol. Venereol. Leprol. 2018, 84, 678–684. [Google Scholar] [CrossRef] [PubMed]
- Dabas, Y.; Xess, I.; Singh, G.; Pandey, M.; Meena, S. Molecular Identification and Antifungal Susceptibility Patterns of Clinical Dermatophytes Following CLSI and EUCAST Guidelines. J. Fungi 2017, 3, 17. [Google Scholar] [CrossRef] [PubMed]
- Rudramurthy, S.M.; Shankarnarayan, S.A.; Dogra, S.; Shaw, D.; Mushtaq, K.; Paul, R.A.; Narang, T.; Chakrabarti, A. Mutation in the Squalene Epoxidase Gene of Trichophyton interdigitale and Trichophyton rubrum Associated with Allylamine Resistance. Antimicrob. Agents Chemother. 2018, 62. [Google Scholar] [CrossRef] [PubMed]
- Bhatia, V.K.; Sharma, P.C. Epidemiological studies on Dermatophytosis in human patients in Himachal Pradesh, India. SpringerPlus 2014, 3, 134. [Google Scholar] [CrossRef] [PubMed]
- Drake, L.A.; Shear, N.H.; Arlette, J.P.; Cloutier, R.; Danbye, F.W.; Elewski, B.E.; Garnis-Jones, S.; Giroux, J.-M.; Gratton, D.; Gulliver, W.; et al. Oral terbinafine in the treatment of toenail onychomycosis: North American multicenter trial. J. Am. Acad. Dermatol. 1997, 37, 740–745. [Google Scholar] [CrossRef]
- Osborne, C.S.; Leitner, I.; Favre, B.; Ryder, N.S. Amino Acid Substitution in Trichophyton rubrum Squalene Epoxidase Associated with Resistance to Terbinafine. Antimicrob. Agents Chemother. 2005, 49, 2840–2844. [Google Scholar] [CrossRef]
- Gregoriou, S.; Mpali, N.; Vrioni, G.; Hatzidimitriou, E.; Chryssou, S.-E.; Rigopoulos, D. Epidemiology of Onychomycosis in an Academic Nail Unit in South Greece during a Three-Year Period. Ski. Appendage Disord. 2020, 6, 102–107. [Google Scholar] [CrossRef] [PubMed]
- Nasr, A.; Vyzantiadis, T.; Patsatsi, A.; Louka, A.; Ioakimidou, A.; Zachrou, E.; Chavale, A.; Kalabalikis, D.; Malissiovas, N.; Sotiriadis, D. Epidemiology of superficial mycoses in Northern Greece: A 4-year study. J. Eur. Acad. Dermatol. Venereol. 2015, 30, 837–839. [Google Scholar] [CrossRef]
- Hayette, M.-P.; Sacheli, R. Dermatophytosis, Trends in Epidemiology and Diagnostic Approach. Curr. Fungal Infect. Rep. 2015, 9, 164–179. [Google Scholar] [CrossRef]
- Badali, H.; Mohammadi, R.; Mashedi, O.; De Hoog, G.S.; Meis, J.F. In vitro susceptibility patterns of clinically important Trichophyton and Epidermophyton species against nine antifungal drugs. Mycoses 2015, 58, 303–307. [Google Scholar] [CrossRef]
- Zalacain, A.; Obrador, C.; Martinez, J.P.; Viñas, M.; Vinuesa, T. Characterization of the antimicrobial susceptibility of fungi responsible for onychomycosis in Spain. Med Mycol. 2010, 49, 1–5. [Google Scholar] [CrossRef]
- Jiang, Y.; Luo, W.; Verweij, P.E.; Song, Y.; Zhang, B.; Shang, Z.; Al-Hatmi, A.M.S.; Ahmed, S.A.; Wan, Z.; Li, R.; et al. Regional Differences in Antifungal Susceptibility of the Prevalent Dermatophyte Trichophyton rubrum. Mycopathologia 2020, 186, 53–70. [Google Scholar] [CrossRef] [PubMed]
- Yenişehirli, G.; Tunçoğlu, E.; Yenisehirli, A.; Bulut, Y. In vitro activities of antifungal drugs against dermatophytes isolated in Tokat, Turkey. Int. J. Dermatol. 2013, 52, 1557–1560. [Google Scholar] [CrossRef]
- Singh, J.; Zaman, M.; Gupta, A.K. Evaluation of microdilution and disk diffusion methods for antifungal susceptibility testing of dermatophytes. Med. Mycol. 2007, 45, 595–602. [Google Scholar] [CrossRef] [PubMed]
- Ghannoum, M.A.; Hajjeh, R.A.; Scher, R.; Konnikov, N.; Gupta, A.K.; Summerbell, R.; Sullivan, S.; Daniel, R.; Krusinski, P.; Fleckman, P.; et al. A large-scale North American study of fungal isolates from nails: The frequency of onychomycosis, fungal distribution, and antifungal susceptibility patterns. J. Am. Acad. Dermatol. 2000, 43, 641–648. [Google Scholar] [CrossRef] [PubMed]
- Silva, L.B.; De Oliveira, D.; Da Silva, B.; De Souza, R.; Da Silva, P.; Ferreira-Paim, K.; Silva-Vergara, M.; Andrade, A. Identification and antifungal susceptibility of fungi isolated from dermatomycoses. J. Eur. Acad. Dermatol. Venereol. 2014, 28, 633–640. [Google Scholar] [CrossRef]
- Bueno, J.G.; Martinez, C.; Zapata, B.; Sanclemente, G.; Gallego, M.; Mesa, A.C. In vitro activity of fluconazole, itraconazole, voriconazole and terbinafine against fungi causing onychomycosis. Clin. Exp. Dermatol. 2009, 35, 658–663. [Google Scholar] [CrossRef]
- Khurana, A.; Masih, A.; Chowdhary, A.; Sardana, K.; Borker, S.; Gupta, A.; Gautam, R.K.; Sharma, P.K.; Jain, D. Correlation of In Vitro Susceptibility Based on MICs and Squalene Epoxidase Mutations with Clinical Response to Terbinafine in Patients with Tinea Corporis/Cruris. Antimicrob. Agents Chemother. 2018, 62. [Google Scholar] [CrossRef]
- Arora, P.; Sardana, K.; Kaur, R.; Goyal, R.; Ghunawat, S. Is antifungal resistance a cause for treatment failure in dermatophytosis: A study focused on tinea corporis and cruris from a tertiary centre? Indian Dermatol. Online J. 2018, 9, 90–95. [Google Scholar] [CrossRef]
- Singh, A.; Masih, A.; Monroy-Nieto, J.; Singh, P.K.; Bowers, J.; Travis, J.; Khurana, A.; Engelthaler, D.M.; Meis, J.F.; Chowdhary, A. A unique multidrug-resistant clonal Trichophyton population distinct from Trichophyton mentagrophytes/Trichophyton interdigitale complex causing an ongoing alarming dermatophytosis outbreak in India: Genomic insights and resistance profile. Fungal Genet. Biol. 2019, 133, 103266. [Google Scholar] [CrossRef]
- Taghipour, S.; Shamsizadeh, F.; Pchelin, I.M.; Rezaei-Matehhkolaei, A.; Mahmoudabadi, A.Z.; Valadan, R.; Ansari, S.; Katiraee, F.; Pakshir, K.; Zomorodian, K.; et al. Emergence of Terbinafine Resistant Trichophyton mentagrophytes in Iran, Harboring Mutations in the Squalene Epoxidase (SQLE) Gene. Infect. Drug Resist. 2020, 13, 845–850. [Google Scholar] [CrossRef]
- Tang, C.; Kong, X.; Ahmed, S.A.; Thakur, R.; Chowdhary, A.; Nenoff, P.; Uhrlass, S.; Verma, S.B.; Meis, J.F.; Kandemir, H.; et al. Taxonomy of the Trichophyton mentagrophytes/T. interdigitale Species Complex Harboring the Highly Virulent, Multiresistant Genotype T. indotineae. Mycopathologia 2021. [Google Scholar] [CrossRef]
- Kano, R.; Kimura, U.; Kakurai, M.; Hiruma, J.; Kamata, H.; Suga, Y.; Harada, K. Trichophyton indotineae sp. nov.: A New Highly Terbinafine-Resistant Anthropophilic Dermatophyte Species. Mycopathologia 2020, 185, 947–958. [Google Scholar] [CrossRef] [PubMed]
- Shaw, D.; Singh, S.; Dogra, S.; Jayaraman, J.; Bhat, R.; Panda, S.; Chakrabarti, A.; Anjum, N.; Chowdappa, A.; Nagamoti, M.; et al. MIC and Upper Limit of Wild-Type Distribution for 13 Antifungal Agents against a Trichophyton mentagrophytes-Trichophyton interdigitale Complex of Indian Origin. Antimicrob. Agents Chemother. 2020, 64. [Google Scholar] [CrossRef]
- Hiruma, J.; Kitagawa, H.; Noguchi, H.; Kano, R.; Hiruma, M.; Kamata, H.; Harada, K. Terbinafine-resistant strain of Trichophyton interdigitale strain isolated from a tinea pedis patient. J. Dermatol. 2018, 46, 351–353. [Google Scholar] [CrossRef]
- Gnat, S.; Łagowski, D.; Nowakiewicz, A.; Dyląg, M.; Osińska, M. Complementary effect of mechanism of multidrug resistance in Trichophyton mentagrophytes isolated from human dermatophytoses of animal origin. Mycoses 2021, 64, 537–549. [Google Scholar] [CrossRef] [PubMed]
- Martinez-Rossi, N.M.; Bitencourt, T.A.; Peres, N.T.A.; Lang, E.A.S.; Gomes, E.V.; Quaresemin, N.R.; Martins, M.; Lopes, L.; Rossi, A. Dermatophyte Resistance to Antifungal Drugs: Mechanisms and Prospectus. Front. Microbiol. 2018, 9, 1108. [Google Scholar] [CrossRef] [PubMed]
- Kimura, U.; Hiruma, M.; Kano, R.; Matsumoto, T.; Noguchi, H.; Takamori, K.; Suga, Y. Caution and warning: Arrival of terbinafine-resistant Trichophyton interdigitale of the Indian genotype, isolated from extensive dermatophytosis, in Japan. J. Dermatol. 2020, 47, e192–e193. [Google Scholar] [CrossRef]
- Kakurai, M.; Harada, K.; Maeda, T.; Hiruma, J.; Kano, R.; Demitsu, T. Case of tinea corporis due to terbinafine-resistant Tri-chophyton interdigitale. J. Dermatol. 2020, 47, e104–e105. [Google Scholar] [CrossRef] [PubMed]
- Hsieh, A.; Quenan, S.; Riat, A.; Toutous-Trellu, L.; Fontao, L. A new mutation in the SQLE gene of Trichophyton mentagrophytes associated to terbinafine resistance in a couple with disseminated tinea corporis. J. Mycol. Médicale 2019, 29, 352–355. [Google Scholar] [CrossRef] [PubMed]
- Sacheli, R.; Harag, S.; Dehavay, F.; Evrard, S.; Rousseaux, D.; Adjetey, A.; Seidel, L.; Laffineur, K.; Lagrou, K.; Hayette, M.-P. Belgian National Survey on Tinea Capitis: Epidemiological Considerations and Highlight of Terbinafine-Resistant T. mentagrophytes with a Mutation on SQLE Gene. J. Fungi 2020, 6, 195. [Google Scholar] [CrossRef] [PubMed]
- Järv, H.; Uhrlass, S.; Simkin, T.; Nenoff, P.; Alvarado Ramirez, E.; Chryssanthou, E.; Monod, M. Terbinafine resistant Trichophyton mentagrophytes genotype VIII, Indian type, isolated in Finland. J. Fungi 2019, 5, 117. [Google Scholar]
- Burmester, A.; Hipler, U.-C.; Hensche, R.; Elsner, P.; Wiegand, C. Point mutations in the squalene epoxidase gene of Indian ITS genotype VIII T. mentagrophytes identified after DNA isolation from infected scales. Med Mycol. Case Rep. 2019, 26, 23–24. [Google Scholar] [CrossRef] [PubMed]
- Łagowski, D.; Gnat, S.; Nowakiewicz, A.; Osińska, M.; Dyląg, M. Intrinsic resistance to terbinafine among human and animal isolates of Trichophyton mentagrophytes related to amino acid substitution in the squalene epoxidase. Infection 2020, 48, 889–897. [Google Scholar] [CrossRef]
- Manoyan, M.; Sokolov, V.; Gursheva, A.; Gabuzyan, N.; Panin, A. Sensitivity of isolated dermatophyte strains to antifungal drugs in the Russian Federation. J. Fungi 2019, 5, 114. [Google Scholar]
- Curatolo, R.; Juricevic, N.; Leong, C.; Bosshard, P.P. Antifungal susceptibility testing of dermatophytes: Development and evaluation of an optimised broth microdilution method. Mycoses 2021, 64, 282–291. [Google Scholar] [CrossRef] [PubMed]
- Verma, S.B. Emergence of recalcitrant dermatophytosis in India. Lancet Infect. Dis. 2018, 18, 718–719. [Google Scholar] [CrossRef]
- Bishnoi, A.; Vinay, K.; Dogra, S. Emergence of recalcitrant dermatophytosis in India. Lancet Infect. Dis. 2018, 18, 250–251. [Google Scholar] [CrossRef]
- Osborne, C.S.; Hofbauer, B.; Favre, B.; Ryder, N.S. In Vitro Analysis of the Ability of Trichophyton rubrum To Become Resistant to Terbinafine. Antimicrob. Agents Chemother. 2003, 47, 3634–3636. [Google Scholar] [CrossRef] [PubMed]
- Ghelardi, E.; Celandroni, F.; Gueye, S.A.; Salvetti, S.; Senesi, S.; Bulgheroni, A.; Mailland, F. Potential of Ergosterol Synthesis Inhibitors To Cause Resistance or Cross-Resistance in Trichophyton rubrum. Antimicrob. Agents Chemother. 2014, 58, 2825–2829. [Google Scholar] [CrossRef]
- Khurana, A.; Sardana, K.; Chowdhary, A. Antifungal resistance in dermatophytes: Recent trends and therapeutic implications. Fungal Genet. Biol. 2019, 132, 103255. [Google Scholar] [CrossRef]
- Araújo, C.R.; Miranda, K.C.; Fernandes, O.D.F.L.; Soares, A.J.; Silva, M.D.R.R. In vitro susceptibility testing of dermatophytes isolated in Goiania, Brazil, against five antifungal agents by broth microdilution method. Rev. Inst. Med. Trop. São Paulo 2009, 51, 9–12. [Google Scholar] [CrossRef] [PubMed]
- Arendrup, M.C.; Jørgensen, K.M.; Guinea, J.; Lagrou, K.; Chryssanthou, E.; Hayette, M.-P.; Barchiesi, F.; Lass-Flörl, C.; Hamal, P.; Dannaoui, E.; et al. Multicentre validation of a EUCAST method for the antifungal susceptibility testing of microconidia-forming dermatophytes. J. Antimicrob. Chemother. 2020, 75, 1807–1819. [Google Scholar] [CrossRef]
- Baghi, N.; Shokohi, T.; Badali, H.; Makimura, K.; Rezaei-Matehkolaei, A.; Abdollahi, M.; Didehdar, M.; Haghani, I.; Abastabar, M. In vitro activity of new azoles luliconazole and lanoconazole compared with ten other antifungal drugs against clinical dermatophyte isolates. Med. Mycol. 2016, 54, 757–763. [Google Scholar] [CrossRef] [PubMed]
- Altinbaş, R.; Özakkaş, F.; Bariş, A.; Turan, D.; Şen, S. In vitro susceptibility of seven antifungal agents against dermatophytes isolated in İstanbul. Turk. J. Med. Sci. 2018, 48, 615–619. [Google Scholar] [CrossRef]

| Species (No of Isolates) | Antifungal Agent | Number of Isolates with MIC (mg/L) of: | MIC50/MIC90 | GM MIC | % Non-WT Phenotype | ||||||||||
|---|---|---|---|---|---|---|---|---|---|---|---|---|---|---|---|
| ≤0.008 | 0.016 | 0.03 | 0.06 | 0.125 | 0.25 | 0.5 | 1 | 2 | 4 | 8 | |||||
| T. rubrum (n = 70) | TRB | 2 | 29 | 39 | - | - | - | - | - | - | - | - | 0.03/0.03 | 0.022 | 0% |
| VRC | - | 3 | 16 | 31 | 20 | - | - | - | - | - | - | 0.06/0.125 | 0.060 | 0% | |
| ITC | - | 1 | 20 | 21 | 21 | 7 | - | - | - | - | - | 0.06/0.25 | 0.069 | 0% | |
| AMO | - | 7 | 24 | 31 | 8 | - | - | - | - | - | - | 0.06/0.125 | 0.045 | 0% | |
| T. interdigitale (n = 12) | TRB | 6 | 3 | 3 | - | - | - | - | - | - | - | - | ≤0.008/0.03 | 0.013 | 0% |
| VRC | - | 2 | 3 | 5 | 2 | - | - | - | - | - | - | 0.06/0.125 | 0.046 | 0% | |
| ITC | 1 | 1 | 6 | 4 | - | - | - | - | - | - | - | 0.03/0.06 | 0.032 | 0% | |
| AMO | - | - | 3 | 5 | 4 | - | - | - | - | - | - | 0.06/0.125 | 0.064 | 0% | |
| T. mentagrophytes (n = 24) | TRB | 1 | 4 | 7 | 3 | - | 2 a | - | - | 4 a | 2 a | 1 a | 0.03/4 | 0.127 | 37.5% b |
| VRC | - | 1 | 1 | 6 | 9 | 4 | 3 | - | - | - | - | 0.125/0.5 | 0.120 | 0% b | |
| ITC | - | 2 | 5 | 7 | 9 | 1 | - | - | - | - | - | 0.06/0.125 | 0.065 | 0% b | |
| AMO | - | - | 1 | 1 | 8 | 13 | 1 | - | - | - | - | 0.25/0.25 | 0.176 | 0% b | |
| T. tonsurans (n = 6) | TRB | - | 6 | - | - | - | - | - | - | - | - | - | 0.016/0.016 | 0.016 | 0% b |
| VRC | - | - | 1 | 2 | 1 | 2 | - | - | - | - | - | 0.06/0.25 | 0.097 | 0% b | |
| ITC | - | - | 3 | 3 | - | - | - | - | - | - | - | 0.03/0.06 | 0.042 | 0% b | |
| AMO | - | 3 | 1 | - | 2 | - | - | - | - | - | - | 0.016/0.125 | 0.035 | 0% b | |
| Isolate | Gender/ Age (Years) | Tinea Infection | Nationality; Additional Remarks | Sampling Date | Antifungals MICs (mg/L); Interpretation | Amino Acid Substitution within the SQLE (Codon Change) | |||
|---|---|---|---|---|---|---|---|---|---|
| TRB | VRC | ITC | AMO | ||||||
| AUH1273 | M/67 | Tinea cruris | Greek Prior use of ointments of azoles | 05/2018 | 8 | 0.06 WT | 0.03 WT | 0.25 WT | Phe397Leu (TTC→TTA) |
| AUH1357 | F/42 | Tinea cruris | Greek Resident of a Roma camp Prior use of ointments of azoles and systemic/topical treatment with TRB | 08/2018 | 2 | 0.06 WT | 0.03 WT | 0.25 WT | Leu393Ser (TTA→TCA) |
| AUH1665 | F/42 (Same as AUH1357) | Tinea cruris and tinea corporis | No improvement after use of ointments of azoles and systemic treatment with TRB | 13/11/2019 | 2 | 0.06 WT | 0.03 WT | 0.25 WT | Leu393Ser (TTA→TCA) |
| AUH1678 | F/42 (Same as AUH1357) | 28/11/2019 | 2 | 0.125 WT | 0.06 WT | 0.25 WT | Leu393Ser (TTA→TCA) | ||
| AUH1598 | M/33 | Tinea cruris | Iranian Prior use of ointments of azoles | 08/2019 | 0.25 | 0.25 WT | 0.125 WT | 0.125 WT | Leu393Ser (TTA→TCA) |
| AUH1621 | M/69 | Tinea cruris and tinea corporis | Greek No prior use of antifungals—improvement after use of ointments of azoles and systemic treatment with ITC | 10/2019 | 2 | 0.125 WT | 0.06 WT | 0.125 WT | Phe397Leu (TTC→TTA) |
| AUH1650 | M/0.8 | Tinea cruris | Syrian Resident of a refugee camp Prior use of ointments of azoles | 10/2019 | 0.25 | 0.5 WT | 0.125 WT | 0.25 WT | Leu393Ser (TTA→TCA) |
| AUH1687 | M/24 | Tinea cruris | Greek Prior use of ointments of azoles and systemic treatment with TRB | 11/2019 | 4 | 0.03 WT | 0.016 WT | 0.125 WT | Phe397Leu (TTC→TTA) |
| AUH1745 | F/90 | Tinea corporis | Greek Prior systemic treatment with FLC | 12/2019 | 4 | 0.5 WT | 0.06 WT | 0.25 WT | Phe397Leu (TTC→TTA) |
| Country | Type of Study | Sampling Year | Tinea Infection | No of Isolates | AST Method (Protocol) | TRB MIC (mg/L); % of Non-WT Isolates | Other Antifungals Tested against TRB Non-WT Isolates (MIC (mg/L), % of Non-WT Isolates) | Amino Acid Substitution within the SQLE (Codon Change) |
|---|---|---|---|---|---|---|---|---|
| Denmark [38] | Case report | ND | Tinea corporis, tinea pedis | 1 | BMD (EUCAST E.Def 9.3) | 4; 100% | FLC (4, 0%) ITC (0.125, 0%) ISA (0.125, 0%) VRC (0.125, 0%) POS (0.03, 0%) | Phe397Leu [7] (NA) |
| Denmark [39] | Case report | ND | Tinea corporis | 1 | BMD (EUCAST E.Def 9.3) | >4; 100% | ITC (0.03, 0%) | Phe397Leu [7] (NA) |
| Denmark [7] | Case series | ND | Various typesof tinea | 10 | BMD (EUCAST E.Def 11.0) | 0.125–>8; 100% | ND | Phe397Leu (n = 4) Leu393Ser (n = 2) b Leu393Phe (n = 1) Phe415Ser (n = 1) c His440Tyr, Phe484Tyr (n = 1) c Ile121Met, Val237Ile (n = 1) c (NA) |
| India [6] | Multicenter laboratory-based (screening of Trichophyton spp. clinical isolates) | 2017–2019 | Various typesof tinea (mainly tinea corporis and tinea cruris) | 18 | Agar screening(SDA containing TRB 0.2 mg/L) BMD (CLSI M38-A2) | 0.03–8; 44% | NA d | Phe397Leu (TTC→CTC) |
| India [44] | Single-center laboratory-based (screening of Trichophyton spp. clinical isolates recovered from recalcitrant/refractory cases) | 2014–2017 | Various typesof tinea (mainly tinea corporis and tinea cruris) | 13 | BMD (CLSI M38-A2) | 0.125–8; 54% | NA d | ND |
| India [45] | Single-center laboratory-based (screening of Trichophyton spp. clinical isolates recovered from recurrent cases) | 2015 | Various typesof tinea (mainly tinea corporis and tinea cruris) | 29 | BMD (CLSI M38-A2) | 0.016–16; 10% | NA d | ND |
| India [46] | Single-center laboratory-based (screening of Trichophyton spp. clinical isolates) | 2014–2015 | Tinea corporis, tinea cruris | 5 | BMD (CLSI M38-A2) | 0.03–8; 40% | NA d | ND |
| India [47] | Single-center laboratory-based (screening of Trichophyton spp. clinical isolates) | 2014 | Various typesof tinea (mainly tinea corporis and tinea cruris) | 35 | BMD (CLSI M38-A2) | 0.016–16; 14% | NA d | Phe397Leu (n = 1) (TTC→CTC) WT (n = 3) (-) |
| India [31] | Multicenter laboratory-based (screening of Trichophyton spp. clinical isolates) [48] | ND | Various typesof tinea (mainly tinea corporis and tinea cruris) | 18 | BMD (CLSI M38-A2) | 0.03–4; 11% | NAd | ND |
| Iran [8] | Multicenter laboratory-based (screening of Trichophyton spp. clinical isolates) | ND | Tinea corporis, tinea pedis | 20 | BMD (CLSI M38-A2) | 0.004–> 32; 10% | LLC (NA, 0%) d | Leu393Phe (n = 1) (TTA→TTT) WT (n = 1) (-) |
| Japan [32] | Multicenter laboratory-based (screening of Trichophyton spp. clinical isolates) | 2020 | Various typesof tinea (mainly tinea pedis and tinea corporis) | 128 | Agar screening(SDA containing TRB 1 mg/L) BMD (CLSI M38-A2) | 32–>32; 4% | ITC (≤0.03–0.25, 0%) RVC (≤0.03–0.06, 0%) LLC (≤0.03, 0%) | Leu393Phe (1179A→C/T) |
| Japan [37] | Case report | 2017 2019 | Tinea unguium (fingernails) | 2 a | BMD (CLSI M38-A2) | 8–16; 100% | ITC (0.06–0.25, 0%) RVC (≤0.03, 0%) | Phe397Leu (TTC→TTA) |
| Japan [40] | Case report | 2016 | Tinea pedis | 1 | BMD (CLSI M38-A2) | >128; 100% | ITC (0.03, 0%) | Leu393Phe (TTA→TTC) |
| Malaysia [41] | Single-center laboratory-based (screening of Trichophyton spp. clinical isolates) | 2012–2013 | Various types of tinea | 3 | BMD (CLSI M38-A2) | 2–4; 100% | AMB (0.06–0.125, 0%) ITC (0.5, 0%) CLT (0.06–0.125, 0%) KTC (0.25–0.5, 0%) MCZ (0.5, 0%) | ND |
| United States of America [36] | Case report | ND | Tinea corporis, tinea unguium (toenails) | 1 | BMD (CLSI M38-A2) | >0.5; 100% | FLC (≤0.03, 0%) | ND |
| North America [43] | Case report | ND [49] | Tinea unguium (toenails) | 6 a | BMD (CLSI M27-A) | 4; 100% | FLC (0.25–0.5, 0%) ITC (≤0.06, 0%) GRS (0.125–0.5, 0%) | Leu393Phe [50] (TTA→TTC) |
| Switzerland [9] | Multicenter laboratory-based (screening of Trichophyton spp. clinical isolates) | 2013–2016 | Tinea unguium, tinea pedis | 1644 | Agar screening(SDA containing TRB 0.2 mg/L) BMD only for TRB non-WT isolates (CLSI M38-A2) | 1–>128; 1% | ND | Leu393Phe (n = 4) (TTA→TTT) Leu393Ser (n = 2) (TTA→TCA) Phe397Leu (n = 4) (TTC→TTA/TTC→CTC) Phe397Ile (n = 1) (TTC→ATC) Phe397Val (n = 1) (TTC→GTC) Phe415Ile (n = 1) b (TTC→ATC) Phe415Ser (n = 1) (TTC→TCC) Phe415Val (n = 1) (TTC→GTC) His440Tyr (n = 1) b (CAT→TAT) |
| Switzerland [42] | Case report | ND | ND | 1 | BMD (CLSI M38-A) | 64; 100% | FLC (NA, 0%) ITC (NA, 0%) GRS (NA, 0%) | Phe397Leu (TTC→TTA) |
| Country | Type of Study | Sampling Year | Tinea Infection | No of Isolates (Species) | AST Method (Protocol) | TRB MIC (mg/L); % of Non-WT Isolates | Other Antifungals Tested against TRB Non-WT Isolates (MIC (mg/L), % of Non-WT Isolates) | Amino Acid Substitution within the SQLE (Codon Change) |
|---|---|---|---|---|---|---|---|---|
| Belgium [75] | Multicenter laboratory-based (screening of Trichophyton spp. clinical isolates) | 2018 | Tinea capitis | 5 (Tm) | BMD (EUCAST E.Def 11.0) | 0.016–4; 20% | ITC (0.016, 0%) VRC (0.5, 0%) AMO (0.06, 0%) | Phe397Leu (NA) |
| Denmark [7] | Case series | ND | Various typesof tinea | 2 (Ti) | BMD (EUCAST E.Def 11.0) | >4–>8; 100% | ND | Phe397Leu (n = 1) Leu393Phe (n = 1) (NA) |
| Finland [76] | Case series | 2019 | Tinea cutis glabrae | 4 (Tm VIII) | BMD (ND) | 4–>8 (data available only for non-WT isolates); 75% | ND | ND |
| Germany [12] | Case series | 2016–2020 (72% during 2019–2020) | Various types of tinea (mainly tinea corporis and tinea cruris) | 29 (Tm VIII) | Agar screening (SDA containing TRB 0.2 mg/L) BMD (CLSI M38-A2) | <0.2–16; 45% | ITC (0.008–0.5, 20%) a VRC (0.008–0.25, 20%) a | Phe397Leu (n = 10) (TTC→CTC/TTC→TTA) Phe397Leu, Ala448Thr (n = 2) (TTC→CTC, GCT→ACT) Leu393Phe (n = 1) (TTA→TTC) |
| Germany [77] | Case report | 2019 | Tinea corporis, tinea cruris | 1 (Tm VIII) | ND | ND | ND | Phe397Leu (TTC→CTC) |
| Germany [26] | Case report | ND | Tinea corporis | 1 (Tm VIII) | Agar screening(SDA containing TRB 0.2 mg/L) | ND | ND | Phe397Leu (TTC→TTA) |
| Greece (present study) | Single-center laboratory-based (screening of Trichophyton spp. clinical isolates) | 2010–2019 | Various types of tinea | 24 (Tm) | BMD (EUCAST E.Def 11.0) | 0.008–8; 37.5% (all Tm VIII) | ITC (0.016–0.125, 0%) VRC (0.03–0.5, 0%) AMO (0.125–0.5, 0%) | Leu393Ser (n = 5) (TTA→TCA) Phe397Leu (n = 4) (TTC→TTA) |
| India [6] | Multicenter laboratory-based (screening of Trichophyton spp. clinical isolates) | 2017–2019 | Various types of tinea (mainly tinea corporis and tinea cruris) | 279 (Tm VIII) | Agar screening(SDA containing TRB 0.2 mg/L) BMD (CLSI M38-A2) | 0.125–16; 71% | NA d | Phe397Leu (n = 153) (1189T→C/1191C→A/G) Phe397Leu, Ala448Thr (n = 27) (1189T→C/1191C→A/G, 1342G→A) Leu393Ser (n = 7) b (1178T→C) Leu393Phe (n = 6) (1179A→C) His440Tyr (n = 2) c (1318C→T) Gln408Leu, Ala448Thr (n = 2) b (1223A→T, 1342G→A) Ser443Pro (n = 1) c (1327T→C) Ser395Pro, Ala448Thr (n = 1) c (1183T→C, 1342G→A) |
| India [68] | Multicenter laboratory-based (screening of Ti/Tm clinical isolates) | 2014–2018 | Various types of tinea | 498 (Ti/Tm) | BMD (CLSI M38-A2) | 0.016–32; 11% | NA d | Phe397Leu (n = 43) (NA) WT (n = 14) (-) |
| India [64] | Multicenter laboratory-based (screening of Trichophyton spp. clinical isolates) | 2014–2018 | Various types of tinea (mainly tinea corporis and tinea cruris) | 129 (Ti/Tm) | BMD (CLSI M38-A2) | 0.125–32; 37% | ITC (0.06–2, 2%) VRC (0.03–0.5, 0%) FLC (0.5–64, 20%) LLC (0.004–0.03, 0%) CLT (1–8, 78%) MCZ (0.5–4, 80%) KTC (0.25–8, 9%) GRS (2–>8, 100%) STC (0.125- > 16, 35%) | Phe397Leu (n = 39) Leu393Phe (n = 7) (NA) |
| India [33] | Single-center laboratory-based (screening of Trichophyton spp. clinical isolates) | 2017 | Various types of tinea (mainly tinea corporis and tinea cruris) | ND (97 patients with Tm infection) | BMD (CLSI M38-A2) | 2–16 (data available only for non-WT isolates); 15 isolates obtained from 13 patients (13%) | ND | Phe397Leu (TTC→CTC/TTC→TTA) |
| India [62] | Single-center laboratory-based (screening of Trichophyton spp. clinical isolates) | 2016–2017 | Tinea corporis, tinea cruris | 64 (Ti) | BMD (CLSI M38-A2) | 0.25–>32; 61% | NA d | Phe397Leu (n = 10) a Leu393Phe (n = 3) WT (n = 4) (NA) |
| India [10] | Multicenter laboratory-based (screening of Trichophyton spp. clinical isolates) | 2015–2017 | Various types of tinea (mainly tinea corporis and tinea cruris) | 63 (Ti) | BMD (CLSI M38-A2) | 0.06–>32; 32% | ITC (0.06–> 16, 25%) VRC (0.06–> 16, 10%) FLC (0.5–> 64, 80%) LLC (≤ 0.004–0.5, 0%) CLT (2–16, 100%) MCZ (1–> 16, 80%) KTC (0.5–> 32, 35%) GRS (2–> 8, 100%) AMB (0.25–1, 0%) STC (0.5–> 16, 75%) | Phe397Leu (n = 12) Leu393Phe (n = 8) (NA) |
| India [44] | Single-center laboratory-based (screening of Trichophyton spp. clinical isolates recovered from recalcitrant/refractory cases) | 2014–2017 | Various types of tinea (mainly tinea corporis and tinea cruris) | 31 (Tm) | BMD (CLSI M38-A2) | 0.03–16; 74% | NA d | ND |
| India [45] | Single-center laboratory-based (screening of Trichophyton spp. clinical isolates recovered from recurrent cases) | 2015 | Various types of tinea (mainly tinea corporis and tinea cruris) | 36 (Tm) 10 (Ti) | BMD(CLSI M38-A2) | Tm: 0.016–8; 11% Ti: 0.016–8; 10% | NA d | ND |
| India [46] | Single-center laboratory-based (screening of Trichophyton spp. clinical isolates) | 2014–2015 | Various types of tinea (mainly tinea corporis and tinea cruris) | 37 (Ti) | BMD (CLSI M38-A2) | 0.03–16; 8% | NA d | ND |
| India [47] | Single-center laboratory-based (screening of Trichophyton spp. clinical isolates) | 2014 | Various types of tinea (mainly tinea corporis and tinea cruris) | 88 (Ti) | BMD (CLSI M38-A2) | 0.016–32; 17% | NA d | Phe397Leu (n = 4) (TTC→CTC) WT (n = 11) (-) |
| India [31] | Multicenter laboratory-based (screening of Trichophyton spp. clinical isolates) [48] | ND | Various types of tinea (mainly tinea corporis and tinea cruris) | 34 (Tm) | BMD (CLSI M38-A2) | 0.06–4; 24% | NA d | ND |
| Iran [65] | Multicenter laboratory-based (screening of Ti/Tm clinical isolates) | 2016–2018 | Various types of tinea | 45 (28 Tm VIII, 17 Tm) | BMD (CLSI M38-A2) | 0.008–>32; 11% (all Tm VIII) | ITC (0.125–2, NA) LLC (0.004–0.008, 0%) GRS (1–4, NA) EFC (0.002–0.008, 0%) CLT (1–8, NA) AMO (0.5–2, NA) | Phe397Leu, Ala448Thr (n = 4) Leu393Ser, Ala448Thr (n = 4) (NA) |
| Iran [21] | Multicenter laboratory-based (screening of Ti/Tm clinical isolates) | 2016–2018 | Various types of tinea | 140 (45 Tm, 95 Tm) | BMD (CLSI M38-A2) | Tm: 0.004–>32; 11% (all Tm VIII) Ti: 0.004–0.25; 0% | ND | ND |
| Iran [11] | Case series | ND | Various types of tinea | 4 (Tm VIII) | BMD (CLSI M38-A2) | >8; 100% | ITC (≥ 4, 100%) FLC (≥ 16, 100%) VRC (0.25–0.5, 0%) POS (0.03–0.06, 0%) | Phe397Leu (TTC→TTA) |
| Japan [69] | Case report | 2017–2018 | Tinea pedis | 1 (Ti) | BMD for TRB (CLSI M38-A) E-test for ITC | 2; 100% | ITC (0.5, 0%) | WT (-) |
| Japan [73] | Case report | ND | Tinea corporis | 1 (Ti) | BMD (CLSI M38-A2) | 32; 100% | ITC (≤ 0.03, 0%) RVC (≤ 0.03, 0%) | Phe397Leu (NA) |
| Japan [72] | Case report | ND | Tinea corporis, tinea cruris, tinea faciei | 1 (Ti) | BMD (CLSI M38-A2) | >32; 100% | ITC (0.03, 0%) RVC (0.5, 0%) LLC (≤ 0.03, 0%) CLT (4, 100%) MCZ (8, 100%) | Phe397Leu (NA) |
| Poland [78] | Multicenter laboratory-based (screening of Tm isolates) | 2016–2019 | Tinea capitis, tinea unguium | 7 (Tm) | BMD (CLSI M38-A2) | 0.004–32; 14% | NA d | Leu393Phe (NA) |
| Russian Federation [79] | Multicenter laboratory-based (screening of Tm isolates) | 2015–2018 | Strains isolated from symptomatic animals (cats and dogs) | 10 (Tm) | BMD (EUCAST E.Def 9.3.1) | >32 (data available only for non-WT isolates); 40% | ENC (NA, 0%) KTC (NA, 0%) | ND |
| Switzerland [24] | Multicenter laboratory-based (screening of Ti/Tm clinical isolates) | 2009–2019 | Various types of tinea (mainly tinea corporis and tinea faciei) | 162 (Tm) | BMD [80] | >4 (data available only for non-WT isolates); 2% (all Tm VIII) | ITC (NA, 0%) FLC (NA, 0%) KTC (NA, 0%) GRS (NA, 0%) | Phe397Leu (NA) |
| Switzerland [9] | Multicenter laboratory-based (screening of Trichophyton spp. clinical isolates) | 2013–2016 | Tinea unguium | 412 (Ti) | Agar screening(SDA containing TRB 0.2 mg/L) BMD only for TRB non-WT isolates (CLSI M38-A2) | 32; 0.2% | ND | Phe397Leu (TTC→CTC) |
| Switzerland [80] | Single-center laboratory-based (screening of Trichophyton spp. clinical isolates) | ND | ND | 7 (Tm) | BMD [80] | ≤0.004–>8; 14% | NA d | Phe397Leu(NA) |
| Switzerland [74] | Case report | ND | Tinea corporis | 2 (Tm) | BMD for TRB (CLSI M38-A) Sensititre YeastOne for azoles | >1; 100% | ITC (0.016, 0%) POS (0.008, 0%) | Gln408Leu (CAA→CTA) |
Publisher’s Note: MDPI stays neutral with regard to jurisdictional claims in published maps and institutional affiliations. |
© 2021 by the authors. Licensee MDPI, Basel, Switzerland. This article is an open access article distributed under the terms and conditions of the Creative Commons Attribution (CC BY) license (https://creativecommons.org/licenses/by/4.0/).
Share and Cite
Siopi, M.; Efstathiou, I.; Theodoropoulos, K.; Pournaras, S.; Meletiadis, J. Molecular Epidemiology and Antifungal Susceptibility of Trichophyton Isolates in Greece: Emergence of Terbinafine-Resistant Trichophytonmentagrophytes Type VIII Locally and Globally. J. Fungi 2021, 7, 419. https://doi.org/10.3390/jof7060419
Siopi M, Efstathiou I, Theodoropoulos K, Pournaras S, Meletiadis J. Molecular Epidemiology and Antifungal Susceptibility of Trichophyton Isolates in Greece: Emergence of Terbinafine-Resistant Trichophytonmentagrophytes Type VIII Locally and Globally. Journal of Fungi. 2021; 7(6):419. https://doi.org/10.3390/jof7060419
Chicago/Turabian StyleSiopi, Maria, Ioanna Efstathiou, Konstantinos Theodoropoulos, Spyros Pournaras, and Joseph Meletiadis. 2021. "Molecular Epidemiology and Antifungal Susceptibility of Trichophyton Isolates in Greece: Emergence of Terbinafine-Resistant Trichophytonmentagrophytes Type VIII Locally and Globally" Journal of Fungi 7, no. 6: 419. https://doi.org/10.3390/jof7060419
APA StyleSiopi, M., Efstathiou, I., Theodoropoulos, K., Pournaras, S., & Meletiadis, J. (2021). Molecular Epidemiology and Antifungal Susceptibility of Trichophyton Isolates in Greece: Emergence of Terbinafine-Resistant Trichophytonmentagrophytes Type VIII Locally and Globally. Journal of Fungi, 7(6), 419. https://doi.org/10.3390/jof7060419








